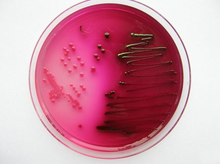

Escherichia coli
| Escherichia coli | ||||||||||||
|---|---|---|---|---|---|---|---|---|---|---|---|---|
.jpg)
E. coli (elektronenmikroskopische Aufnahme) | ||||||||||||
| Systematik | ||||||||||||
| ||||||||||||
| Wissenschaftlicher Name | ||||||||||||
| Escherichia coli | ||||||||||||
| (Migula 1895) Castellani & Chalmers 1919 |

Escherichia coli (abgekürzt E. coli) – auch Kolibakterium (lateinisch Bacterium coli) genannt – ist ein gramnegatives, säurebildendes und peritrich begeißeltes Bakterium, das normalerweise im menschlichen und tierischen Darm vorkommt. Unter anderem auf Grund dessen gilt dieses Bakterium auch als Fäkalindikator. E. coli und andere fakultativ anaerobe Organismen machen etwa 1 ‰ der Darmflora aus.
Innerhalb der Familie der Enterobakterien (altgriechisch ἕντερον, lateinisch enteron „Darm“) gehört E. coli zur bedeutenden Gattung Escherichia und ist deren Typspezies. Benannt wurde es nach dem deutschen Kinderarzt Theodor Escherich, der es isolierte und 1886 erstmals beschrieb. Coli ist der lateinische Genitiv von colon (zu dt. Kolon), einem Teil des Dickdarms.
Die meisten Angehörigen dieser Spezies sind nicht krankheitsauslösend, jedoch gibt es auch zahlreiche verschiedene pathogene Stämme. Es zählt zu den häufigsten Verursachern von menschlichen Infektionskrankheiten. Die Basensequenz des Genoms einiger Stämme ist vollständig aufgeklärt. Als Modellorganismus zählt es zu den am besten untersuchten Prokaryoten und nimmt in der Molekularbiologie eine wichtige Rolle als Wirtsorganismus ein. Der Nobelpreis für Physiologie oder Medizin wurde an zahlreiche Forscher, die sich mit der Biologie von E. coli beschäftigt haben, vergeben.
Merkmale

E. coli hat die Form gerader, zylindrischer Stäbchen mit runden Enden. Der Durchmesser beträgt 1,1–1,5 µm und die Länge 2,0–6,0 µm. Sie kommen paarweise oder einzeln vor. In der Gram-Färbung verhalten sie sich negativ (gramnegativ). Es bildet keine Bakteriensporen, Die Zellen bestehen überwiegend (70–85 %) aus Wasser, wobei die Trockenmasse zu 96 % aus Polymeren besteht, unter denen die Proteine dominieren. Es sind 4288 unterschiedliche Proteine annotiert. Im Cytoplasma und in der Zellhülle (bestehend aus Zellmembran, Periplasma, äußere Membran) erfüllen sie strukturelle, enzymatische und regulatorische Funktionen. Das Genom umfasst etwa 4600 Kilobasenpaare und kommt als kovalent in sich geschlossenes Bakterienchromosom vor.
Fimbrien

Viele Stämme besitzen Fimbrien (Pili). Eine Zelle des Stammes K-12 enthält typischerweise etwa 100–500 Typ 1 Fimbrien mit einer Länge von 0,2–2,0 µm und einem Durchmesser von ca. 7 nm. Es gibt mehr als 30 verschiedene Arten von Fimbrien, die in zwei nach ihren adhesiven Eigenschaften an rote Blutkörperchen eingeteilt werden: MS (Mannose-sensitive), die in Anwesenheit von Mannose rote Blutkörperchen nicht verklumpen können (Hämagglutination) und MR (Mannose-resistente), denen die Präsenz des Zuckers nichts ausmacht. Typ 1 Fimbrien, die zu den MS-Fimbrien gehören, kommen sowohl in symbiotischen als auch in pathogenen Stämmen vor und werden daher nicht zur Differenzierung herangezogen. MR-Fimbrien sind serologisch divers und fungieren häufig als Virulenzfaktoren. Ihr Anhaften ist sowohl spezies- als auch organspezifisch. Zusätzlich bildet E. coli einen Sexpilus aus (auch F-Pilus, F für Fertilität), mit dem Zell-Zell-Kontakte zum Austausch von genetischer Information (Konjugation) möglich sind. Zudem dient der F-Pilus einigen Bakteriophagen als Rezeptor, nach deren Bindung die Virus-DNA eingeschleust wird (Transduktion).
Bewegung

Zellen von E. coli können sich durch peritriche Begeißelung aktiv bewegen (sie sind motil) oder sie sind – seltener – zur aktiven Bewegung unfähig. Motile E. coli bewegen sich mit ihrem proteinösen Flagellum fort, wobei sie wiederholt ihre Richtung ändern: Ein Bakterium bewegt sich in eine Richtung fort, indem sich die Flagellen bündeln und zusammenarbeiten. Die Fortbewegung wird zeitweise kurz durch Taumeln unterbrochen, indem sich das Flagellenbündel auflöst und die einzelnen Flagellen sich in verschiedene Richtungen wenden. Danach reformiert sich das Flagellenbündel und beschleunigt das Bakterium in eine neue Richtung. Die Stabilität des Bündels wird durch Chemorezeptoren verstärkt. Bietet man den Bakterien einen Nährstoff an, so wird die Stabilität des Flagellenbündels weiter verstärkt, und die Bakterien akkumulieren.
E. coli ist chemotaktisch: Schwimmen die Individuen in einem Konzentrationsgefälle eines Lockstoffs in Richtung ansteigender Konzentration, so ändern sie weniger häufig ihre Richtung. Schwimmen sie ein Konzentrationsgefälle herunter, ist ihr Bewegungsmuster nicht von dem in einer isotropen Lösung zu unterscheiden, und sie ändern häufiger die Richtung. Neben positiver Chemotaxis kann E. coli sich auch aktiv von Schadstoffen entfernen (negative Chemotaxis), wobei niedrige Konzentrationen an Schadstoffen keine Lockstoffe darstellen und hohe Nährstoffkonzentration nicht abstoßend wirken. Es gibt Mutanten, die gewisse Schadstoffe nicht erkennen, und nicht-chemotaktische Mutanten, die auch keine Lockmittel erkennen können. Der Prozess benötigt L-Methionin.
Die Signaltransduktion für akkurate chemotaktische Reaktionen hat sich im Laufe der Evolution auf optimale Arbeitsleistung bei minimaler Proteinexpression entwickelt. Aufgrund des hohen Selektionsdrucks ist die Chemotaxis bei E. coli sehr sensitiv, besitzt ein schnelles Ansprechverhalten und ist perfekt angepasst. Zudem scheint die Anordnung innerhalb des bakteriellen chemosensorischen Systems hochkonserviert.
Membranproteine
Zum Stoffaustausch besitzt E. coli Transportproteine in der Zellmembran. Unter den Porinen dominieren Outer-membrane-Proteine OmpF und OmpC, welche zwar nicht substratspezifisch sind, jedoch kationische und neutrale Ionen bevorzugen und hydrophobe Verbindungen nicht akzeptieren. Die Kopienzahl hängt von der Osmolarität der Umgebung ab und dient der Anpassung an den Lebensraum. Unter den Bedingungen im Dickdarm (Hyperosmolarität, höhere Temperatur) überwiegen OmpC-Kanäle. Verlässt das Bakterium seinen Wirt und findet sich in einem weniger bevorzugten Lebensraum, z. B. einem Gewässer (niedrigere Osmolarität und Temperatur), so wird die OmpF-Synthese gefördert. Für Substrate, die durch die unspezifischen Porine gar nicht oder unzureichend transportiert werden, gibt es substratspezifische Porine. Bei Phosphatmangel exprimiert E. coli das Protein PhoE. Zusammen mit Maltodextrinen entstehen daraus Maltoporine, die auch als Rezeptor für die Lambda-Phage fungieren und daher auch LamB genannt werden. Stämme, die Saccharose verwerten können, nehmen diese über das Kanalprotein ScrY auf. Langkettige Fettsäuren werden mit FadL in die Zelle transportiert.
Stoffwechsel
E. coli ist heterotroph, fakultativ anaerob und besitzt die Fähigkeit, Energie sowohl durch die Atmungskette als auch durch „Gemischte Säuregärung“ zu gewinnen. Die Gärungsbilanz bei E. coli sieht folgendermaßen aus:
Glucose wird von E. coli unter Säurebildung vergoren, was mit Methylrot als pH-Indikator nachgewiesen werden kann. Neben Säure bildet E. coli aus Glucose auch Gase. Der Indol-Test auf Tryptophanase ist positiv. Die Voges-Proskauer-Reaktion zum Nachweis der Acetoin-Bildung fällt negativ aus. Auf Simmons Citrat-Agar ist keine Verfärbung sichtbar, da E. coli Citrat nicht als alleinige Energiequelle nutzen kann. Zudem kann es Malonat nicht verwerten. Acetat und Tartrat können verstoffwechselt werden (Test mit Methylrot nach Jordan). Nitrat kann zu Nitrit reduziert werden. Auf Triple Sugar Iron-Agar wird kein Schwefelwasserstoff gebildet. E. coli kann keinen Harnstoff und keine Gelatine hydrolysieren, einige Stämme jedoch Esculin. Lysin wird von vielen Stämmen decarboxyliert, Ornithin nur von wenigen. Im Kaliumcyanid-Wachstumstest wächst E. coli nicht. Es besitzt keine Phenylalanindeaminase, keine Lipase und keine DNase im engeren Sinne. Der Oxidase-Test mit Kovacs-Reagenz ist stets negativ. Des Weiteren kann von den meisten Stämmen L-Arabinose, Lactose, Maltose, D-Mannitol, D-Mannose, Mucinsäure, D-Sorbitol, Trehalose und D-Xylose fermentativ genutzt werden.
Serotypen

Die Serotypisierung ist eine nützliche Möglichkeit, E. coli anhand der zahlreichen Unterschiede in der Antigenstruktur auf der Bakterienoberfläche einzuteilen.
Man unterscheidet vier Gruppen von Serotypen:
- flagellare H-Antigene für die Flagellen, abgeleitet von „mit Hauch wachsende Bakterien“, da sie durch ihre aktive Fortbewegung auf einer Agarplatte ein mattes Kräuselmuster erzeugen, das wie eine angehauchte Glasplatte aussieht. Es handelt sich um Proteinantigene.
- somatische O-Antigene, abgeleitet von „ohne Hauch“ für die Lipopolysaccharide, die sich auf der Oberfläche der Zellwand befinden. Ihre Spezifität wird durch Kohlenhydratseitenketten bestimmt. Zurzeit sind etwa 190 verschiedene O-Antigene bekannt.
Selten zur Diagnostik eingesetzt werden:
- K-Antigene für die Kapsel, die aus Polysacchariden aufgebaut sind
- fimbriale F-Antigene für die Fimbrien
Vorkommen
E. coli kommt als universeller und kommensaler Begleiter im unteren Darmtrakt warmblütiger Tiere (inklusive des Menschen) vor. Im Stuhl befinden sich etwa 108–109 koloniebildende Einheiten pro g. Es kann auch in anderen Habitaten überleben. Bei Neugeborenen spielt es als Erstbesiedler eine wichtige Rolle. Obwohl es selbst nur in geringer Zahl vorhanden ist, dient es der Ansiedlung obligater Anaerobier, die physiologische Bedeutung bei der Verdauung besitzen. Trotz des geringen Anteils im Darm nimmt E. coli eine beherrschende Stellung im Darm ein, den es bei Menschen innerhalb von 40 Stunden nach der Geburt über Lebensmittel, Wasser oder andere Individuen kolonisiert. Die Fähigkeit zum Anhaften an den Mucus erlaubt E. coli, lange Zeit im Darm zu verweilen. Obwohl sehr viel über den Organismus bekannt ist, weiß man über seine Ökologie im Darm relativ wenig.
Als Kommensale im Darm
E.coli lebt normalerweise regelmäßig im Darm von Menschen und einer Vielzahl anderer Wirbeltiere, einschließlich Reptilien. Die bakterielle Besiedlung des Darms ist für seine normale Funktion und für ein funktionierendes Immunsystem essentiell und wird als Darmflora bezeichnet. Wie fast alle anderen spezialisierten Arten der Darmflora lebt E.coli fast ausschließlich im Dickdarm (vor allem im Colon). Die Darmflora (etwa 400 bis 500 Arten, vor allem Bacillota (Firmicutes) und Bacteroidetes) besteht weit überwiegend aus anaeroben Arten. Aerobe und faktultativ anaerobe Arten, zu denen E.coli gehört, machen zusammen nur etwa 0,1 Prozent der Individuendichte aus. Unter diesen ist E.coli die häufigste Art. Die Prävalenz der Art im menschlichen Darm liegt bei 90 Prozent, zum Vergleich: bei wild lebenden Säugetieren 56 %, bei Vögeln 23 %, bei Reptilien nur 10 %. Die Häufigkeit (gemessen als koloniebildende Einheit) pro Gramm von menschlichen Kot liegt in der Größenordnung von Zehntausenden bis Millionen. E.coli lebt normalerweise nicht im Darmlumen, sondern kolonisiert die den Darm auskleidende, von der Schleimhaut abgegebene Schleimschicht. Bei der Erneuerung der Schicht wird sie mit dieser zusammen abgegeben und mit dem Kot ausgeschieden.
Die den Darm bewohnenden E.coli bilden keine einheitliche Population. Der Wildtyp besteht aus einer Vielzahl von Stämmen, die sich in ihrem Genom und damit in ökologischen und metabolischen Eigenschaften dramatisch unterscheiden, so dass nur ein Kerngenom von wenigen Prozent zwischen allen identisch ist. E.coli wird Neugeborenen dabei nicht von der Mutter mitgegeben, sondern die Stämme werden nach und nach mit der Nahrung aus der Umwelt aufgenommen. Einzelne Menschen unterscheiden sich dabei stark voneinander, wobei die Darmflora umso ähnlicher ist, je näher sie zusammenleben. Dies betrifft sogar Menschen und Haustiere im selben Haushalt. Unterschieden werden residente Stämme, die mindestens einige Wochen nachweisbar sind, und transiente, die nur kurze Zeit nachweisbar bleiben. Durch Untersuchung von Reisenden oder Migranten ist bekannt, dass sich das Mikrobiom des Darms mit Ankunft in neue Umgebung nach und nach den dort vorherrschenden Stämmen angleicht. Die Details von Konkurrenz und ggf. Kommensalismus zwischen verschiedenen Stämmen sind dabei noch weitgehend unverstanden. Sie sind von medizinischer Bedeutung, wenn es um die Etablierung pathogener Stämme geht.
Lebensmittelhygiene
Sporadische durch Trinkwasser übertragene Ausbrüche von enterotoxischen Stämmen (ETEC) sind bekannt. Zudem werden ETEC durch Konsum von Weichkäse und rohem Gemüse übertragen. Ausbrüche von enteropathogenen Stämmen (EPEC) werden häufig mit kontaminiertem Trinkwasser und einigen Fleischprodukten in Verbindung gebracht. Infektionen mit enterohämorrhagischen E. coli (EHEC) stammen häufig von Lebensmitteln oder geschehen mittels Wasser. Häufig infizierte Lebensmittel sind nicht durchgegartes Rinderhack, Rohmilch, kalte Sandwiches, Wasser, nicht-pasteurisierter Apfelsaft, Sprossen und rohes Gemüse. Zudem standen Epidemien im Zusammenhang mit Hamburgern, Roastbeef, Kohlrouladen und Rohwurst (Teewurst).
In 1–2 % des Rinderkots kann der für Rinder ungefährliche magensäureresistente Stamm Escherichia coli O157:H7 (EHEC) nachgewiesen werden, welcher bei der Schlachtung auch das Fleisch kontaminieren und bei Menschen schwere Lebensmittelvergiftungen auslösen kann. Der Grund hierfür ist, dass häufig stärkehaltiges Getreide gefüttert wird, das im Pansen unvollständig abgebaut und zu Säure fermentiert wird, so dass sich acidophile Bakterien dort anreichern. Die Fütterung von Heu oder Gras reduziert die Anzahl humanpathogener Stämme.
Da eine komplette EHEC-Sanierung der Tierbestände nicht möglich ist, muss die Prophylaxe bei der Schlachthygiene ansetzen. Rindfleischprodukte sollten mindestens 10 Minuten bei mindestens 70 °C durchgegart werden. Aufgrund der hohen Umweltresistenz der Erreger sollten Lebensmittelhersteller Belastungstests und HACCP-Analysen durchführen. Risikogruppen (Kinder unter 6 Jahren und immunsupprimierte Personen) sollten rohe Produkte nicht verzehren.
Badegewässer
Nach der EU-Badegewässerrichtlinie von 2006 gelten für E. coli folgende Grenzwerte:
- „Ausgezeichnete Qualität“ bis 500 KbE / 100 ml
- „Gute Qualität“ bis 1000 KbE / 100 ml
Gemäß Trinkwasserverordnung gilt hingegen ein restriktiver Grenzwert von 0 KbE / 100 ml.
Sandstrände können besonders von E. coli betroffen sein, da der Abbau der Abwasserbakterien im Sand länger dauert als im Meerwasser.
Medizin
Probiotikum
Der Stamm Escherichia coli Alfred Nissle 1917 (Handelsname Mutaflor) zählt zu den am häufigsten untersuchten Probiotika. Er wurde während des Balkankriegs vom Stuhl eines Soldaten isoliert, der im Gegensatz zu seinen Kameraden nicht an Durchfall litt. Der Stamm ist mittlerweile sequenziert und besitzt sechs verschiedene Systeme, um Eisen aufzunehmen, wodurch er Konkurrenten aus dem Feld schlägt. Er besitzt Adhäsine für eine effektive Kolonisierung und blockiert das Anhaften und Eindringen von pathogenen Bakterien an die Epithelzellen des Darms. Zudem besitzt er einen entzündungshemmenden Effekt auf die T-Zellen-Proliferation. Des Weiteren wird die Produktion von menschlichem β-Defensin 2 angeregt, das als Breitspektrumantibiotikum sowohl grampositive als -negative Bakterien, Pilze und Viren abtötet.
Humanpathogenität
Die meisten Stämme von E. coli sind nicht pathogen und damit harmlos. Einige Serotypen spielen jedoch eine wichtige Rolle bei Erkrankungen innerhalb und außerhalb des Darms. In Wirten mit Immunschwäche ist E. coli ein opportunistischer Erreger, das heißt, erst durch die Schwächung des Wirts kann er wirksam werden. Uropathogene E. coli (UPEC) sind für unkomplizierte Harnwegsinfektionen verantwortlich. Neonatale Meningitis auslösende E. coli (NMEC) können die Blut-Hirn-Schranke passieren und bei Neugeborenen eine Hirnhautentzündung auslösen. NMEC und UPEC führen im Blutstrom zur Sepsis.
Es wird vermutet, dass E. coli mit chronisch-entzündlichen Darmerkrankungen wie Morbus Crohn und Colitis ulcerosa assoziiert ist, da neben genetischer Prädisposition und Umweltfaktoren an der Krankheitsentstehung unter anderem auch eine fehlregulierte Immunantwort der Schleimhaut gegen kommensale Bakterien beteiligt sein könnte. Die Schleimhaut der Patienten ist abnormal mit adhärent-invasiven E. coli (AIEC) kolonisiert, welche an den Epithelzellen anhaften und in sie eindringen.
Die darmpathogenen E. coli werden in fünf verschiedene Pathogruppen unterteilt. Weltweit verursachen sie jährlich 160 Mio. Durchfallerkrankungen und 1 Mio. Todesfälle. In den meisten Fällen sind Kinder unter 5 Jahren in den Entwicklungsländern betroffen.
Enteropathogene E. coli
Enteropathogene E. coli (kurz EPEC) sorgen bei Kleinkindern für schwere Durchfälle, die in industrialisierten Gesellschaften selten, in unterentwickelten Ländern jedoch häufig für kindliche Todesfälle verantwortlich sind. Mithilfe des EPEC Adhäsionsfaktor (EAF) heften sich die EPEC an die Epithelzellen des Dünndarms und injizieren dann Toxine in die Enterozyten mit Hilfe eines Typ-III-Sekretionssystems. Es existieren auch sogenannte atypische EPEC. Sie zeigen die bei STEC gängigen Serotypen sowie Virulenz- und Pathogenitätsfaktoren wie beispielsweise das eae-Gen. Den Stx-Prophagen und die damit zugehörigen für STEC charakteristischen stx-Gene haben sie jedoch wahrscheinlich verloren.
Enterotoxische E. coli
Enterotoxische E. coli (kurz ETEC) sind häufiger Erreger der Reisediarrhoe („Montezumas Rache“). Grund für diese Erkrankung ist ein hitzelabiles Enterotoxin vom A/B Typ (LT I und LT II) sowie ein hitzestabiles Enterotoxin (ST). Dieses 73 kDa große Protein besitzt zwei Domänen, von denen sich eine an ein G-Gangliosid der Zielzelle bindet (Bindende Domäne). Die andere Domäne ist die Aktive Komponente, die ähnlich dem Choleratoxin (etwa 80 % Genhomologie) die Adenylatcyclase aktiviert. Das etwa 15–20 Aminosäuren lange ST aktiviert die Guanylatcyclase. Die Aktivierung der Adenylatcyclase und der Guanylatcyclase endet in einer sekretorischen Diarrhoe, bei der viel Wasser und Elektrolyte verloren gehen.
Enteroinvasive E. coli
Enteroinvasive E. coli (kurz EIEC) penetrieren die Epithelzellen des Kolons und vermehren sich dort. Innerhalb der Zelle kommt es zur Aktinschweifbildung, womit sie in benachbarte Zellen eindringen können. Es kommt zu Entzündungen und Geschwürbildung unter Absonderung von Blut, Schleim und weißen Blutkörperchen (Granulozyten). Zudem können EIEC Enterotoxine abgeben, die Elektrolyt- und Wasserverlust in den befallenen Zellen versursachen. Das Krankheitsbild ähnelt einer Bakterienruhr mit Fieber und blutig-schleimigen Durchfällen, wobei häufig eine abgeschwächte Symptomatik mit wässriger Diarrhoe einhergeht.
Enterohämorrhagische E. coli
Enterohämorrhagische E. coli (kurz EHEC) sind Shiga-Toxin produzierende E. coli (STEC) mit zusätzlichen Pathogenitätsfaktoren. Das Shigatoxin wirkt enterotoxisch und zytotoxisch und zeigt Ähnlichkeiten mit dem von Shigellen gebildeten Toxin. Analog werden VTEC (Vero-Toxin produzierende E. coli) benannt. Durch EHEC verursachte Darmerkrankungen wurden vornehmlich unter dem Namen enterohämorrhagische Colitis bekannt. EHEC-Infektionen zählen zu den häufigsten Ursachen für Lebensmittelvergiftungen. Der Erreger ist hoch infektiös: 10 – 100 Individuen sind für eine Erkrankung ausreichend. Die niedrige Infektionsdosis begünstigt eine Übertragung von Mensch zu Mensch. Eine Infektion kann jedoch auch durch Tierkontakt (Zoonose) oder durch Verschlucken von Badewasser erfolgen. Typische Krankheitsbilder sind die thrombotisch-thrombozytopenische Purpura (TTP) und ein hämolytisch-urämisches Syndrom (HUS). Gefürchtet ist vor allem HUS aufgrund der Möglichkeit, an einem terminalen Nierenschaden zu sterben. Hierbei sind alle Altersgruppen betroffen, jedoch vor allem Kinder unter 6 Jahren. Das Nierenversagen verläuft in 10 – 30 % der Fälle mit dem Tod des Patienten innerhalb eines Jahres nach Beginn der Erkrankung.
Enteroaggregative E. coli
Enteroaggregative E. coli (EAggEC oder EAEC abgekürzt) besitzen die Fähigkeit zur Autoaggregation. Sie heften sich mit spezifischen Fimbrien an das Dünndarmepithel. Charakteristisch ist die erhöhte Schleimproduktion der Mukosazellen, die eine Ausscheidung verzögert. Es kommt zu einer Diarrhoe vom sekretorischen Typ aufgrund von Enterotoxinen (EAST). Durch EAEC werden sowohl akute als auch chronisch rezidivierende Durchfallerkrankungen, die sich über Wochen hinziehen können, verursacht. Neben wässrig schleimigem Durchfall kann es auch zu Fieber und Erbrechen oder blutigem Stuhl kommen. Bei Immunsupprimierten (z. B. HIV-Patienten) ist EAEC der häufigste Erreger einer bakteriellen Enteritis.
Zoopathogenität
E. coli ist für eine Vielzahl von Infektionskrankheiten bei Tieren verantwortlich. Spezifische veterinärmedizinische Krankheitsbilder sind:
- Coliruhr der Saug- und Absatzferkel
- Coliseptikämie der Kälber und Lämmer
- Coliseptikämie des Geflügels
- Colimastitis der Kühe
Beim Hausschwein lösen extraintestinal pathogene (ExPEC) Stämme eine hämorrhagische Septikämie aus, die als Differentialdiagnose zur Klassische Schweinepest" klassischen Schweinepest angesehen wird.
Labordiagnose

Coliforme Bakterien werden als Indikator für die sanitäre Gewässergüte und die Hygiene bei der Lebensmittelverarbeitung verwendet. Fäkalcoliforme Keime gelten insbesondere bei Schalentieren als der Standardindikator für Verunreinigung. E. coli zeigt fäkale Verunreinigung sowie unhygienische Verarbeitungen an. Klassischerweise basieren die biochemischen Methoden zum Nachweis von E. coli, Gesamtcoliformen oder Fäkalcoliformen auf der Verwertung von Lactose. Eine Auszählung ist mittels MPN-Verfahren möglich. Gebräuchlich ist eine Brillantgrün-Galle-Lactose-Bouillon in denen Gasbildung beobachtet wird. Es gibt jedoch auch spezielle Nährböden wie Eosin-Methylen-Blau, VRB-Agar (Kristallviolett-Neutralrot-Galle-Agar), MacConkey-Agar und Endo-Agar, die Lactoseverwertung anzeigen. Zur Differenzierung von anderen Enterobakterien kann der IMViC-Test durchgeführt werden.
Pathogene E. coli werden ebenfalls zunächst angereichert. Das hitzelabile Enterotoxin (LT) der ETEC kann durch einen Y-1-Nebennieren-Zell-Assay, Latexagglutinations-Assay und ELISA nachgewiesen werden. Der Nachweis für das hitzestabile Toxin (ST) der ETEC kann ebenfalls mittels ELISA oder Jungmaus-Assay erfolgen. Die Gene für LT und ST sind bekannt und können mittels PCR oder mittels Gensonde nachgewiesen werden. In Verbindung mit Ausplattierung auf Agarkulturmedien können so ETEC-positive Kolonien gezählt werden. EIEC sind nicht-motil und anaerogen, da sie kein Lysin decarboxylieren und keine Lactose fermentieren. Der invasive Phänotyp von EIEC, der durch ein hochmolekulares Plasmid codiert wird, kann mittels HeLa-Zellen oder Hep-2-Gewebezellkulturen nachgewiesen werden. Alternativ können PCR- und Sondenmethoden für die Invasionsgene eingesetzt werden. Das Protein Intimin der EPEC wird durch ein eae-Gen codiert auf das mit PCR getestet werden kann. Des Weiteren wird der EPEC-adhärent-Faktor (EAF) über ein Plasmid codiert. Das Protein lässt sich mit Hep-2-Zellen nachweisen. EHEC kann über die Shiga-Toxine (Stx) nachgewiesen werden. Insbesondere Stx1 und Stx2 werden mit menschlichen Erkrankungen in Zusammenhang gebracht, wobei zahlreiche Varianten von Stx2 existieren. Die Produktion von Stx1 und Stx2 kann mit Zytotoxizitätstests auf Vero-Zellen oder Hela-Gewebekulturen sowie durch ELISA und Latexaggulationstests erfolgen. Zudem gibt es PCR-Assays für Stx1, Stx2 oder andere charakteristische Marker. EHEC zeichnen sich zudem durch keine oder langsame Fermentation von Sorbitol aus. Eine weitere biochemische Differenzierung ist der LST-MUG-Assay, welcher auf der enzymatischen Aktivität von β-Glucuronidase (GUD) basiert. GUD setzt das Substrat 4-Methylumbelliferyl-β-D-glucuronid (MUG) in4-Methylumbelliferon um, welches bei 365 nm (UV-Licht) eine blaue Fluoreszenz zeigt. GUD wird von > 95 % der E. coli-Stämme produziert (inklusive denen, die kein Gas produzieren), jedoch nicht von EHEC des Serotyps O157:H7, weshalb es hier zur Differenzierung verwendet werden kann.
Therapie
Die Therapie bei fakultativ pathogenen Stämmen sollte immer gezielt nach Antibiogramm erfolgen. E. coli-Arten (insbesondere ESBL-Stämme im Gegensatz zum Wildtyp, der gut sensibel gegen Cephalosporine ist) besitzen Antibiotikaresistenzen durch die Bildung zahlreicher β-Lactamasen, die in der Lage sind, β-Lactam-Antibiotika zu spalten (ESBL-Stämme, die resistent gegen alle β-Lactama-Antibiotika außer Carbapenem resistent sind, sind zudem häufig multiresistent – auch gegenüber Chinolonen).
Mittel der Wahl sind Aminopenicilline, Ureidopenicilline, Cephalosporine (idealerweise ab der 2. Generation), Carbapeneme, Chinolon-Antibiotika und Cotrimoxazol. Aminoglycoside werden in Ausnahmesituationen kombiniert.
Bei Befall der Harnwege eignen sich insbesondere Cotrimoxazol (bei Sensitivität) und Cefuroxim, alternativ auch Levofloxacin, Ciprofloxacin und Fosfomycin; bei Bakteriämie und Sepsis Cefotaxim und Ceftriaxon, und alternativ Levofloxacin und Ciprofloxacin. Bei einer Meningitis durch E. coli eignen sich Ceftriaxon, Cefotaxim und alternativ Meropenem. Infektionen mit ESBL-positiven Stämmen werden mit Ertapenem, Imipenem, Meropenem, Levofloxacin oder (wenn sensibel) mit Ciprofloxacin therapiert.
Bei obligat pathogenen E.-coli-Stämmen sind die Gastroenteritidien selbstlimitierend. Der starke Flüssigkeitsverlust muss jedoch insbesondere bei Säuglingen und Kleinkindern behandelt werden. Für den Wasser- und Salzverlust bieten sich orale Rehydratationslösungen an. Die zweimalige Gabe von Antibiotika (z. B. Ciprofloxacin und Cotrimoxazol) innerhalb von 24 h kann Dauer und Schwere der Erkrankung lindern.
Eine rasche Keimzahlreduktion kann nur bei sehr frühem Einsatz erzielt werden. Bei der Therapie von enterohämorrhagischen E. coli mit Antibiotika kann es durch vermehrte Ausschüttung von Vero-Toxin zu Komplikationen kommen. Insbesondere bei der Gabe von Fluorchinolonen, Cotrimoxazol, Aminoglycosiden und Fosfomycin überwiegen die ungünstigen Wirkungen. Dies gilt nicht in gleichem Maße für Carbapeneme. Auch der Einsatz neuerer Makrolide und gegebenenfalls von Clindamycin sowie Rifampicin und Rifaximin bei gegebener Indikation (z. B. Sanierung von Meningokokken-Trägern) scheint nicht kontraindiziert. Jedoch bleibt der Einsatz dieser Substanzen im Sinne einer EHEC-Virulenzabschwächung durch Reduktion der Verotoxinproduktion kontrovers.
Meldepflicht
In Deutschland ist der direkte oder indirekte Nachweis von Escherichia coli (enterohämorrhagische Stämme (EHEC) und sonstige darmpathogene Stämme)
namentlich meldepflichtig nach
![]() § 7 des
Infektionsschutzgesetzes, soweit der Nachweis auf eine akute Infektion hinweist.
§ 7 des
Infektionsschutzgesetzes, soweit der Nachweis auf eine akute Infektion hinweist.
Forschun
Geschichte
Entdeckt wurde E. coli 1885 von Theodor Escherich, der es damals „Bacterium coli commune“ nannte. 1919 wurde es ihm zu Ehren umbenannt. 1892 wurde von Shardinger vorgeschlagen, E. coli als Indikatororganismus für fäkale Verunreinigung zu verwenden. In der Praxis war es jedoch schwierig, mit rein biochemischen Nachweismethoden E. coli von anderen Enterobakterien abzugrenzen, weshalb die nicht taxonomische Bakteriengruppe coliforme Bakterien definiert wurde. 1997 wurde die DNA-Sequenz aufgeklärt. Hierfür wurden 15 Jahre benötigt.
Phylogenie
| ||||||||||||||||||||||||||||||||||||||||||||||||||||||||||||||||||||||||||||||||||||||||||||||||||||||||||||||||||||||||||||||||||||||||||||||||||||||
| Kladogramm mit 26 vollständig sequenzierten
E.coli-Stämmen, berechnet durch Orthologiebestimmung aller Gene.
Mit Hilfe von |
Das Kerngenom, das sich in allen Stämmen wiederfindet, macht lediglich 6 % der Genfamilien aus. Über 90 % der Gene sind variabel. Die Diversität innerhalb der Spezies und die überlappenden Geninhalte mit verwandten Spezies lassen einen Übergang anstelle einer scharfen Speziesabgrenzung innerhalb der Enterobacteriaceae vermuten. Insbesondere zwischen der Gattung Shigella und enteroinvasiven E. coli gibt es eine enge evolutionäre Verwandtschaft sowohl in der chromosomalen DNA als auch bei dem Virulenzplasmid.
Man unterscheidet anhand von phylogenetischen Analysen vier Hauptgruppen (A, B1, B2, und D), wobei die virulenten extraintestinalen Stämme hauptsächlich zu den Gruppen B2 und D gehören. Innerhalb der Gattung Escherichia ist E. fergusonii die nächste verwandte Art.
Der extraintestinal pathogene (ExPEC) Serotyp O7:K1 (Stamm IAI39) löst beim Hausschwein eine hämorrhagische Septikämie aus. Er hat keine ETEC (enterotoxische) oder EDEC (Ödemkrankheit-verursachende E. coli) Virulenzfaktoren. Stattdessen besitzt er P-Fimbrien und Aerobactin Stamm SMS-3-5 / SECEC wurde in einem küstennahen Industriegebiet, mit Schwermetallen verseuchtem Gebiet isoliert. Es ist gegen zahlreiche Antibiotika in hohen Konzentrationen resistent.
Serotyp O127:H6, Stamm E2348/69 war der erste sequenzierte und am besten untersuchte enteropathogene E. coli (EPEC).
Im Vergleich mit anderen pathogenen Stämmen zeigt CFT073 des Serotyps O6:H1 das Fehlen eines Typ-III-Sekretionssystems und keine phagen- oder plasmidcodierten Toxine. Stattdessen besitzt er fimbriale Adhäsine, Autotransporter, Eisen-Sequestierungssysteme und Rekombinasen. Schlussfolgernd kann man sagen, dass extraintestinal pathogene E. coli unabhängig voneinander entstanden sind. Die verschiedenen Pathotypen haben hohe Syntenie, die durch vertikalen Gentransfer entstanden ist und ein gemeinsames Rückgrat bildet, das durch zahlreiche Inseln aufgrund von horizontalem Gentransfer unterbrochen wird.
Der Serotyp O45:K1 (Stamm S88 / ExPEC) wurde 1999 aus der Zerebrospinalflüssigkeit eines spät ausbrechenden Meningitisfalles in Frankreich isoliert. Er gehört zur phylogenetischen Gruppe B2. Der Serotyp O1:K1 löst bei Vögeln Krankheiten aus und wird „avian pathogen Escherichia coli“ (APEC) genannt. Er ist mit drei menschlichen uropathogenen (UPEC) eng verwandt. UTI89 ist ein uropathogener E.-coli-Stamm, der aus einem Patienten mit akuter Blaseninfektion isoliert wurde. Der Stamm ED1a ist hingegen apathogen und wurde aus dem Stuhl eines gesunden Mannes isoliert. Der uropathogene Stamm 536 (O6:K15:H31) stammt ursprünglich von einem Patienten mit akuter Pyelonephritis. Er ist ein Modellorganismus für extrainstestinale E. coli. Das Genom enthält fünf gut charakterisierte Pathogenitätsinseln und eine neu entdeckte sechste, die den Schlüsselvirulenzfaktor darstellt.
Der gefürchtete Lebensmittelvergifter E. coli O157:H7 wurde vollständig sequenziert, um seine Pathogenität zu verstehen. Die Erklärung liefert ein massiver lateraler Gentransfer. Über 1000 neue Gene finden sich in diesem stammspezifischen Cluster. Enthalten sind mögliche Virulenzfaktoren, alternative metabolische Fähigkeiten sowie zahlreiche Prophagen, die für die Lebensmittelüberwachung genutzt werden können. Das Virulenzplasmid pO157 besitzt 100 offene Leserahmen. Ein ungewöhnlich großes Gen hat ein mutmaßliches aktives Zentrum, das mit der Familie des großen clostridialen Toxins (LCT) und Proteinen wie ToxA und B von Clostridium difficile verwandt ist. Der Stamm TW14359 wurde 2006 nach einem Ausbruch von E. coli O157:H7 in den USA aus Spinat isoliert. Es wurden neue Genabschnitte festgestellt, welche die erhöhte Fähigkeit zur Auslösung des hämolytisch-urämischen Syndroms oder alternativ die Anpassung an Pflanzen erklären. Zudem enthält der Stamm Gene für intakte anaerobe Nitritreduktasen.
Der Serotyp O139:H28 (Stamm E24377A / ETEC) ist ein enterotoxisches Isolat. Er besitzt das Kolonisationsfaktorantigen (colonization factor antigen, CFA) Pili, um sich anzuheften. 4 % des Genoms bestehen aus Insertionssequenzen. Vermutlich kann der Stamm Propandiol als einzige Kohlenstoffquelle verwerten. Stamm 55989 / EAEC ist ein enteroaggregativer Stamm, der 2002 in der Zentralafrikanischen Republik aus dem Stuhl eines HIV-positiven Erwachsenen, der an stark wässrigem Durchfall litt, isoliert wurde.
Der Stamm IAI1 vom Serotyp O8 ist ein bei Menschen kommensaler Stamm, der aus den Fäzes eines gesunden Franzosen in den 1980ern isoliert wurde. Bakterien des Stammes SE11 vom Serotyp O152:H28 wurden ebenfalls aus den Fäzes eines gesunden Menschen isoliert. Im Vergleich mit dem Laborstamm K-12 MG1655 besitzt der Stamm zusätzliche Gene für Autotransporter und Fimbrien, um sich an den Darmzellen zu befestigen. Zudem besitzt er mehr Gene, die für den Kohlenhydratstoffwechsel von Bedeutung sind. Alles deutet darauf hin, dass sich dieser Stamm an den menschlichen Darm angepasst hat. Bakterien des Serotyps O103:H2 (Stamm 12009) wurden 2001 in Japan von einem Patienten mit sporadisch auftretendem blutigen Durchfall isoliert. Offenbar sind EHEC-Stämme mit den gleichen Pathotypen von verschiedener Abstammung unabhängig voneinander durch Lambda-Phagen, Inserationelemente und Virulenzplasmide entstanden.
Crooks (ATCC 8739 / DSM 1576) ist ein fäkaler Stamm, der dazu verwendet wird, die Effizienz antimikrobieller Wirkstoffe zu testen. Er besitzt ein Insertionselement innerhalb von ompC und kann daher nur ompF als äußeres Membranporin exprimieren. Der Stamm B dient als Forschungsmodell für Phagensensitivität, Restriktionsmodifikationssysteme und bakterielle Evolution. Ihm fehlen Proteasen. Zudem produziert er wenig Acetat, wenn ihm viel Glucose angeboten wird. Aufgrund einer einfachen Zelloberfläche ist die selektive Permeabilität verbessert. Daher wird er gerne zur rekombinanten Proteinexpression im Labormaßstab und in industriellen Dimensionen eingesetzt. Der Stamm K12 von MC4100 ist sehr häufig eingesetzt. Eine Genomsequenzierung zeigte, dass er während seiner Anpassung an die Laborumgebung zusätzliche Unterschiede entwickelt hat, die nicht künstlich herbeigeführt wurden. Der Stamm K12 wurde 1922 von einem Patienten mit Diphtherie isoliert und 1925 in die Stammsammlung von Stanford überführt. Da er prototroph und in definiertem Medium mit kurzen Generationszeiten einfach zu züchten ist, wurde er schnell zum bestuntersuchten Organismus und seit den 1950ern zum Verstehen zahlreicher fundamentaler biochemischer und molekularer Prozesse herangezogen. Zudem besitzt er die unter E-coli-Wildtypen seltene Fähigkeit zur Rekombination. Der Stamm DH10B ist ein Derivat von K12, das aufgrund der leichten Transformation insbesondere großer Plasmide (nützlich bei der Genomsequenzierung) vielfach eingesetzt wird. Die Sequenz wurde aus „Kontaminationssequenzen“ bei der Genomsequenzierung des Rindes zusammengesetzt.
Der Serotyp O9:H4 (Stamm HS) wurde von einem Laborwissenschaftler des Walter-Reed-Militärkrankenhauses isoliert. Im Humanexperiment zeigte sich, dass der Stamm HS den Gastrointestinaltrakt kolonisiert, aber keine Krankheitsbilder verursacht. Der Stamm UMN026 ist ein extraintestinal pathogener Stamm (ExPEC), der 1999 in den USA von einem Patienten mit akuter Zystitis isoliert wurde. Er gehört zur phylogenetischen Gruppe D und besitzt den Serotyp O17:K52:H18. Er ist Repräsentant einer Gruppe resistenter Erreger.
Der Serotyp O104:H4 Klon HUSEC041 (Sequenztyp 678) enthält Virulenzfaktoren, die sowohl für STEC als auch für EaggEC typisch sind. Im Zusammenhang mit der HUS-Epidemie 2011 in Norddeutschland wird dieser Hybrid für die besonders schwere Verlaufsform verantwortlich gemacht.
Langzeitexperiment

Seit 1988 führt Richard Lenski ein Langzeitexperiment über die Evolution von E. coli durch. Jeden Tag werden die Kulturen in ein frisches Medium überimpft und tiefgefroren. So können neue besser angepasste Stämme wieder gegen ihre Vorfahren antreten und geprüft werden, ob sie sich besser an ihre Erlenmeyerkolbenumgebung angepasst haben. Es werden parallel die Veränderungen im Genom ermittelt, wobei die Innovationsrate kontinuierlich abnahm, je besser sich die Kulturen angepasst hatten. Es wurden auch Parallelversuche mit Myxococcus xanthus gemacht, das E. coli jagt und frisst, sowie Temperatur und Medium variiert. Unter konstanten Bedingungen ohne Fressfeinde und nur einem Zucker (Glucose) wurde dem Nährmedium auch Citrat zugegeben, obwohl E. coli dieses nicht verwerten kann. Im Jahr 2003 dominierte plötzlich ein Citrat-verwertender Mutant, der nachweislich von der Ursprungskultur abstammte.
Biosensoren
Mittels gentechnisch veränderter E. coli ist es möglich, Biosensoren für Schwermetalle wie Arsen herzustellen. Die natürlichen Mechanismen werden hierbei mit Reportergenen wie β-Galactosidase, bakteriellen Luciferasen (lux) oder dem Grün fluoreszierendem Protein (GFP) gekoppelt. Auf diese Weise ist es möglich, kostengünstig Arsenite und Arsenate unterhalb eines Mikrogramms zu detektieren.
Gentechnik

Die Kombination von ringförmiger separat in der Bakterienzelle vorliegender DNA, den sogenannten Plasmiden, mit der Entdeckung des Restriktionsenzyms EcoRI, das doppelsträngige DNA spezifisch schneidet und identische überstehende Enden zurücklässt, war die Geburtsstunde der Gentechnik. Um rekombinante DNA (künstlich hergestellte DNA) zu erhalten, wird bei einer typischen Klonierung zunächst das DNA-Fragment der Wahl und anschließend die plasmidische DNA eines so genannten Klonierungsvektors mit Restriktionsenzymen geschnitten. Durch eine Ligation werden die Enden des DNA-Fragmentes und des Plasmides zusammengefügt und anschließend in E. coli transformiert. Auf diese Weise können beispielsweise artfremde Gene in E. coli eingebracht werden, sodass dieses die auf der DNA codierten fremden Proteine synthetisieren kann. Aus E. coli wird auch das Restriktionsenzym EcoRV verwendet.

Moderne künstlich hergestellte Plasmide (Vektoren oder „Genfähren“) wie pUC19 enthalten zusätzliche Antibiotika-Resistenzgene um Bakterienzellen ohne einklonierte Plasmide auf Selektivnährböden abzutöten. Eine weitere Möglichkeit zur Selektion transformierter Kolonien ist das blue-white-screening. Das Gen lacZ codiert das Protein β-Galactosidase, welches in Anwesenheit von IPTG synthetisiert wird und das künstliche Glycosid X-Gal in einen blauen Farbstoff spaltet. Nicht-transformierte Zellen erscheinen also blau auf einen Nährboden mit X-Gal. Schneidet ein Restriktionsenzym innerhalb des lacZ-Gens und wird erfolgreich ein Fremdgen eingebracht, so wird die Sequenz zur Expression von β-Galactosidase dermaßen zerstört, dass keine α-Komplementation mehr möglich ist. Erfolgreich transformierte Zellen erscheinen also weiß. Das lacZ dient hierbei somit als Reportergen. Der Test funktioniert nur mit der Deletions-Mutante lacZΔM15, deren defekte β-Galactosidase auf die α-Komplementation angewiesen ist.
ArcticExpress
Zwingt man E. coli zur Überexpression von heterologen Proteinen, kann es zu Problemen bei der Proteinfaltung kommen. Es kommt zur Anhäufung fehlgefalteter und somit biologisch inaktiver Proteine (Einschlusskörperchen). Eine Strategie um die Ausbeute an löslichem Protein zu steigern, ist die Kultivierung bei niedrigen Temperaturen. Hierfür koexprimiert man im mesophilen E. coli die Faltungshelferproteine (Chaperonine) Cpn10 and Cpn60 aus dem psychrophilen Bakterium Oleispira antarctica, die bei 4–12 °C arbeiten. Sie werden unter dem Markennamen ArcticExpress von der Firma Agilent vertrieben. Zusätzlich werden Stämme angeboten, die weitere tRNAs besitzen, um dem limitierenden Codon Bias bei der Translation DNA fremder Organismen in rekombinante Proteine entgegenzuwirken.
XL1-Red
E. coli XL1-Red ist ein Stamm, der in der Molekularbiologie und Gentechnik zur ungerichteten Mutagenese genutzt wird. Durch Defekte im DNA-Reparaturmechanismus zeigt der Stamm eine 5000-fache Mutationsrate gegenüber dem Wildtyp jedoch auch eine deutlich geringere Wachstumsrate (Verdopplung alle 90 min. bei 37 °C). Die Defekte im Reparaturmechanismus der DNA-Vervielfältigung gehen auf drei Mutationen der genomischen DNA zurück. Das Gen MutS enthält Mutationen der DNA-Mismatch-Reparaturproteine. Durch die Mutation erfolgt keine Fehlbasenreparatur nach der DNA-Replikation. MutD löst einen Defekt der 3'-5'-Exonukleaseaktivität der DNA-Polymerase III aus. MutT ist für die Unfähigkeit zur Hydrolyse des Basenanalogons oxo-dGTP verantwortlich. Zur Mutationsauslösung werden also weder Mutagene noch Karzinogene benötigt. Die Generierung von Genmutationen ist ein klassisches Mittel in der molekularbiologischen Forschung, um generelle oder Teilfunktionen des entsprechenden Gens zu charakterisieren.
Biotechnologie
Die erste kommerzielle biotechnologische Anwendung war die Produktion des menschlichen Hormons Somatostatin von der Firma Genentech mittels genetisch veränderten E. coli. Die großtechnische Herstellung von Insulin und Wachstumshormonen folgte kurz darauf. Das derart hergestellte Insulinpräparat wird in der Behandlung von Diabetes mellitus eingesetzt. Hierfür ist E. coli besonders geeignet, da es zur Darmflora des Menschen gehört und so gut wie keine Allergien verursacht. Auch in der industriellen Herstellung von Aminosäuren, Interferon sowie weiterer Feinchemikalien, Enzyme und Arzneistoffe, werden gentechnisch veränderte E. coli Bakterien verwandt. So wurden neun von 31 therapeutischen Proteinen, die im Zeitraum von 2003 bis 2006 eine Arzneimittelzulassung erhalten haben, in E. coli hergestellt.
Um E. coli in biotechnologischen Anwendungen leichter handhaben zu können, züchtete ein Team um Frederick Blattner (University of Wisconsin) einen Stamm, dessen Genom gegenüber natürlich vorkommenden Varianten um ca. 15 Prozent verkleinert wurde, und der dennoch lebens- und fortpflanzungsfähig ist. Hierfür wurden zwei unterschiedliche E. coli Stämme verglichen und diejenigen Gene entfernt, die kein Homolog im jeweils anderen Stamm haben und somit entbehrlich scheinen.
Biotreibstoffe
Die Herstellung von Biotreibstoffen aus Proteinen ist mit genetisch veränderten E. coli, die drei exogene Transaminierungs- und Desaminierungszyklen enthalten, möglich. Die Proteine werden zunächst durch Saccharomyces cerevisiae, Bacillus subtilis, Mikroalgen (zur gleichzeitigen CO2-Fixierung) oder E. coli selbst hergestellt. Die Proteine könnten auch aus Abfällen von Fermentationen, Lebensmittelverarbeitung, und Bioethanolherstellung stammen. Anschließend werden die Hydrolysate in C4- und C5-Alkohole mit 56 % der theoretischen Ausbeute umgewandelt. Der entstehende Stickstoff kann in Düngemittel umgewandelt werden.
Durch Veränderungen im Stoffwechsel von E. coli können höhere Alkohole wie Isobutanol, 1-Butanol, 2-Methyl-1-butanol, 3-Methyl-1-butanolund 2-Phenylethanol aus der C-Quelle Glucose produziert werden. Hierfür wird der hochaktive Biosyntheseweg für Aminosäuren verwendet und die 2-Ketosäureintermediate zur Alkoholsynthese verwendet. Verglichen mit dem klassischen Biotreibstoff Ethanol ist die höhere Energiedichte und die niedrige Hygroskopie hervorzuheben. Zudem haben verzweigtkettige Alkohole höhere Octanzahlen.
Kooperation bei Nährstoffmangel
Bakterien können sich bei Nährstoffmangel gegenseitig helfen. So wurde bei genetisch veränderten Escherichia coli und Acinetobacter baylyi beobachtet, wie sich E. coli mit Acinetobacter baylyi durch bis zu 14 Mikrometer lange Nanokanäle verbunden hat, um zytoplasmatische Bestandteile auszutauschen. Die beiden Bakterien wurden so verändert, dass sie für sich notwendige Aminosäuren nicht mehr produzieren konnten, die für die andere Art notwendigen Aminosäuren aber produzierten. Darauf hin bildete E. coli Nanokanäle aus, um sich mit Acinetobacter baylyi zu verbinden und zu überleben. Unklar ist noch, ob Bakterien gezielt steuern können, an welche Zelle sie sich anheften und ob diese Verbindung parasitischer Natur ist.


© biancahoegel.de
Datum der letzten Änderung: Jena, den: 04.12. 2025